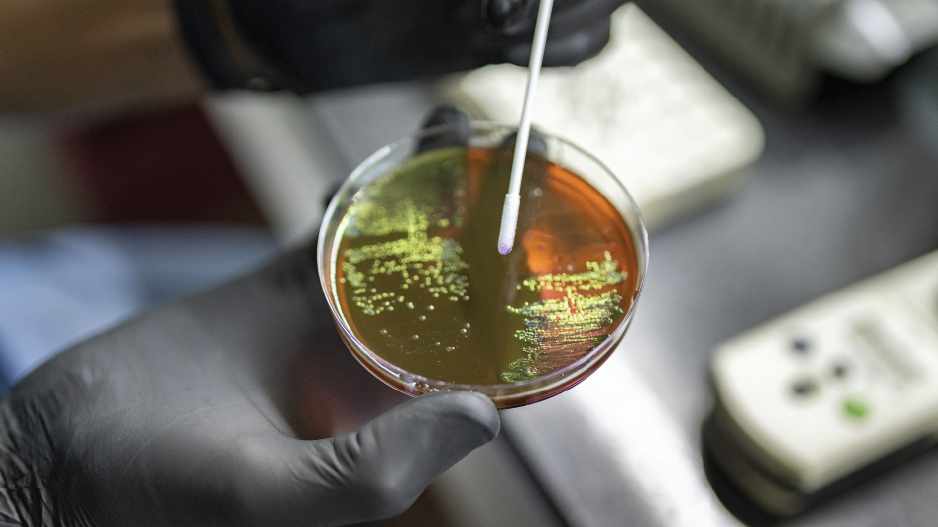

Welcome to the practice of
Dr. Shaharudeen Kamaludeen, Consultant Infectious Diseases Specialist at KPJ Damansara Specialist Hospital. With a strong background in Internal Medicine and Infectious Disease care, Dr. Shaharudeen is dedicated to diagnosing, treating, and preventing infections with a patient-first approach.


About
Dr. Shaharudeen
Dr. Shaharudeen is an Infectious Diseases Specialist with expertise in :-
- Drug-resistant infections
- Tropical diseases
- HIV care
- Infection prevention strategies
He also plays an active role in public health education and medical training, advocating for safer healthcare practices across Malaysia.
What We Offer
Fever of Unknown Origin (FUO)
Thorough evaluation and management of prolonged or unexplained fevers.

Multidrug-Resistant Infections
Treatment of infections caused by resistant bacteria such as MRSA, ESBL, and CRE.
HIV Care & Antiretroviral Therapy
Comprehensive HIV management, including PrEP and PEP services.

Severe Dengue Management
Advanced support for dengue cases with warning signs or complications.

Why Choose Us
Expert in Infectious diseases
Experience in multidrug-resistant and complex infections
Convenient location at KPJ Damansara Specialist Hospital
Patient care in English, Malay & Tamil
A focus on prevention treatment, education, and compassionate support
